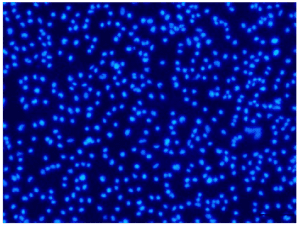

本产品是一种基于 Hoechst 33342【2′-(4-乙氧基苯基)-5-(4-甲基-1-哌嗪基)- 2,5′-双-1H-苯并咪唑三盐酸盐】的荧光染料,广泛应用于细胞成像技术中 DNA 和细胞核染色。其检测原理是 Hoechst 33342 能够渗透细胞膜与 dsDNA 的腺嘌呤-胸腺嘧啶 (A-T)小沟处结合,从而对细胞核染色。Hoechst 33342 本身荧光背景较低,与 dsDNA 结合后发出强烈的蓝色荧光(最大激发光与发射光分别为 Ex = 350 nm,Em = 461 nm)。Hoechst 33342 染色常用于细胞凋亡检测,染色后可用荧光显微镜观察或流式细胞仪检测。Hoechst 33342 也常用于普通的细胞核染色,或常规的 DNA 染色。本产品操作简单,仅需将 Hoechst 33342 溶液稀释至合适浓度后覆盖样本,孵育一定时间后即可观察到明亮的蓝色荧光。
本产品可广泛用于活细胞、固定细胞或组织、石蜡切片的细胞核染色以及细胞凋亡和细胞周期分析。
1. 本产品是即用型染料,操作简单,染色固定细胞或石蜡切片样本时可用 PBS 或细胞培养液将其稀释至工作浓度(0.5~10 μg / ml),加入至细胞中,室温孵育一定时间即可观察;染色活细胞时,该溶液可直接按照一定比例加至细胞培养液中,无需收集细胞,也无需洗涤细胞,37℃孵育一定时间即可观察。
2. 本产品可渗透细胞膜,对细胞毒性较低,适用于活细胞、固定细胞或组织、石蜡切片等多种样本的细胞核染色实验以及细胞凋亡检测。
3. 酚红和血清对 Hoechst 33342 染色无影响。
| 组分 | 规格 |
| Hoechst 33342 Solution(1 mg / ml) | 1 ml |
运输温度:-20℃ 冰袋运输

-scaled-1-scaled.jpg)